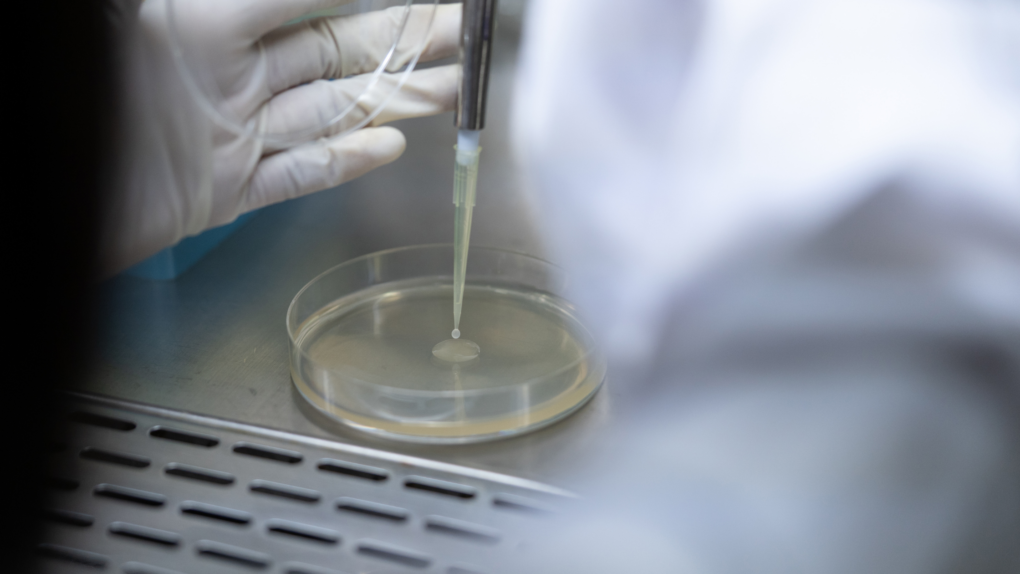
Configura Google Fotos en la nube de forma rápida y sencilla 27 Configuración de calidad de medios

Configura Google Fotos en la nube de forma rápida y sencilla

Imagina tener todas tus fotos y videos almacenados de forma segura en la nube, accesibles desde cualquier dispositivo y sin ocupar espacio en tu teléfono. Esta es la solución que Google Fotos ofrece a aquellos que buscan una manera eficiente de gestionar su biblioteca multimedia. Con la cantidad creciente de contenido visual que generamos a diario, la necesidad de organizar y respaldar nuestras imágenes se vuelve cada vez más apremiante.
Aprenderás paso a paso cómo configurar Google Fotos en la nube, aprovechando al máximo sus funciones de almacenamiento ilimitado y reconocimiento facial. Descubrirás cómo **organizar** tus fotos de manera automática, **compartirlas** con amigos y familiares, y **liberar espacio** en tu dispositivo sin perder tus recuerdos más preciados. Con Google Fotos, podrás disfrutar de una experiencia más fluida y segura en la gestión de tu contenido visual, sin preocuparte por la falta de almacenamiento o la pérdida de archivos importantes. ¡Simplifica tu vida digital y descubre todo lo que esta plataforma tiene para ofrecerte!
- Accede a tu cuenta de Google
- Dirígete a la configuración de Google Fotos
- Selecciona la opción de "Copia de seguridad y sincronización"
- Elige las carpetas que deseas respaldar en la nube
- Asegúrate de tener suficiente espacio de almacenamiento en Google Drive
- Verifica la configuración de calidad de las fotos y videos a respaldar
- Revisa periódicamente la copia de seguridad para garantizar que se esté realizando correctamente
- Accede a tu cuenta de Google
- Dirígete a la configuración de Google Fotos
- Selecciona la opción de "Copia de seguridad y sincronización"
- Elige las carpetas que deseas respaldar en la nube
- Asegúrate de tener suficiente espacio de almacenamiento en Google Drive
- Verifica la configuración de calidad de las fotos y videos a respaldar
- Revisa periódicamente la copia de seguridad para garantizar que se esté realizando correctamente
Accede a tu cuenta de Google

Accede a tu cuenta de Google
Para configurar Google Fotos en la nube, primero accede a tu cuenta de Google desde tu navegador web.
Dirígete a la configuración de Google Fotos

Dirígete a la configuración de Google Fotos
Selecciona la opción de "Copia de seguridad y sincronización"

Selecciona la opción de "Copia de seguridad y sincronización"
Elige las carpetas que deseas respaldar en la nube

Elige las carpetas que deseas respaldar en la nube
Para configurar Google Fotos en la nube de forma rápida y sencilla, sigue estos pasos:
- Abre la aplicación de Google Fotos en tu dispositivo.
- Ve a la sección de ajustes o configuración.
- Selecciona la opción de "Copia de seguridad y sincronización".
- Elige las carpetas que deseas respaldar en la nube marcando las casillas correspondientes.
Asegúrate de tener suficiente espacio de almacenamiento en Google Drive

Asegúrate de tener suficiente espacio de almacenamiento en Google Drive
Antes de configurar Google Fotos en la nube, verifica que dispones de suficiente espacio de almacenamiento en tu cuenta de Google Drive. Puedes comprobarlo accediendo a tu cuenta de Google Drive y revisando la cantidad de espacio disponible.
Verifica la configuración de calidad de las fotos y videos a respaldar

Verifica la configuración de calidad de las fotos y videos a respaldar
Antes de comenzar a configurar Google Fotos en la nube, asegúrate de revisar la calidad en la que deseas respaldar tus archivos. Puedes elegir entre "Alta calidad" (almacenamiento gratuito e ilimitado, con compresión de archivos) o "Original" (almacenamiento limitado a tu cuenta de Google). Para verificar esta configuración:
- Abre la aplicación de Google Fotos en tu dispositivo.
- Toca en tu perfil en la esquina superior derecha.
- Selecciona "Configuración" y luego "Copia de seguridad y sincronización".
- Revisa la opción de calidad de copia de seguridad y elige la que mejor se adapte a tus necesidades.
Revisa periódicamente la copia de seguridad para garantizar que se esté realizando correctamente

Para revisar periódicamente la copia de seguridad en Google Fotos, sigue estos pasos:
- Abre la aplicación de Google Fotos en tu dispositivo.
- Toca en tu perfil en la esquina superior derecha.
- Selecciona "Ajustes" y luego "Copia de seguridad y sincronización".
- Verifica que la copia de seguridad esté activada y que las carpetas que deseas respaldar estén seleccionadas.
- Desplázate hacia abajo y revisa la última copia de seguridad realizada para asegurarte de que se haya completado correctamente.
Accede a tu cuenta de Google

Accede a tu cuenta de Google
Para configurar Google Fotos en la nube, primero accede a tu cuenta de Google siguiendo estos pasos:
- Abre un navegador web.
- Ingresa a la página de Google en www.google.com.
- Haz clic en el botón "Iniciar sesión" en la esquina superior derecha.
- Ingresa tu dirección de correo electrónico y contraseña.
- Presiona el botón "Siguiente" y habrás accedido a tu cuenta de Google.
Dirígete a la configuración de Google Fotos

Dirígete a la configuración de Google Fotos
Selecciona la opción de "Copia de seguridad y sincronización"
![]()
Selecciona la opción de "Copia de seguridad y sincronización"
Elige las carpetas que deseas respaldar en la nube

Elige las carpetas que deseas respaldar en la nube
Para configurar Google Fotos en la nube de forma rápida y sencilla, sigue estos pasos:
- Abre la aplicación de Google Fotos en tu dispositivo.
- Ve a la sección de "Ajustes" o "Configuración".
- Selecciona la opción de "Copia de seguridad y sincronización".
- Activa la copia de seguridad de las carpetas que deseas respaldar en la nube.
Asegúrate de tener suficiente espacio de almacenamiento en Google Drive

Asegúrate de tener suficiente espacio de almacenamiento en Google Drive
Antes de configurar Google Fotos en la nube, verifica que dispones de suficiente espacio de almacenamiento en tu cuenta de Google Drive. Puedes comprobarlo accediendo a tu cuenta de Google y revisando la cantidad de espacio disponible.
Verifica la configuración de calidad de las fotos y videos a respaldar
Verifica la configuración de calidad de las fotos y videos a respaldar
Antes de comenzar a configurar Google Fotos en la nube, asegúrate de revisar la calidad en la que se respaldarán tus archivos. Puedes elegir entre:
- Alta calidad: Fotos y videos comprimidos para ahorrar espacio.
- Calidad original: Mantienen la resolución original, pero pueden ocupar más espacio.
Revisa periódicamente la copia de seguridad para garantizar que se esté realizando correctamente
Es importante revisar periódicamente la copia de seguridad en Google Fotos para asegurarte de que se esté realizando correctamente. Sigue estos pasos:
- Abre la aplicación de Google Fotos en tu dispositivo.
- Toca en tu perfil en la esquina superior derecha.
- Selecciona "Configuración" y luego "Copia de seguridad y sincronización".
- Verifica que la copia de seguridad esté activada y revisa la última vez que se realizó.
Preguntas frecuentes
¿Cuánto espacio de almacenamiento ofrece Google Fotos de forma gratuita?
Google Fotos ofrece almacenamiento gratuito ilimitado para fotos y videos de alta calidad. Sin embargo, las fotos y videos en calidad original cuentan hacia el límite de almacenamiento de 15 GB compartido con otros servicios de Google.
¿Cómo puedo activar la copia de seguridad automática en Google Fotos?
Para activar la copia de seguridad automática en Google Fotos, solo necesitas abrir la aplicación, ir a Configuración, seleccionar Copia de seguridad y sincronización, y activar la opción. Asegúrate de estar conectado a una red Wi-Fi para evitar consumir datos móviles.
Si quieres conocer otros artículos parecidos a Configura Google Fotos en la nube de forma rápida y sencilla puedes visitar la categoría Información.
